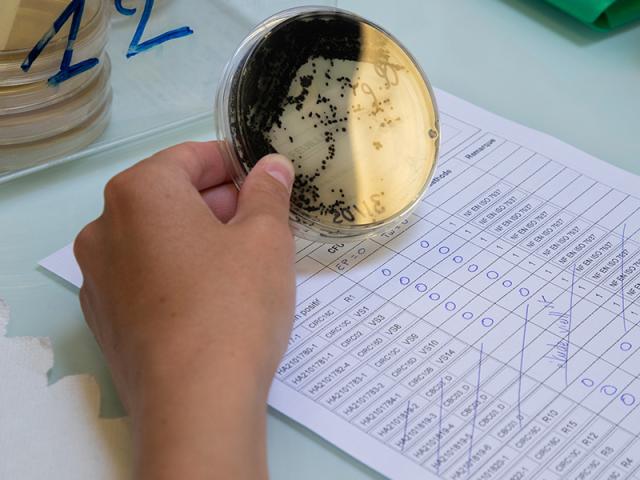
laboratoire

Protéger le vivant
La Gironde confrontée à l’érosion de la biodiversité
De nombreuses espèces animales et végétales disparaissent à un rythme accéléré depuis 150 ans dans le monde.
La Gironde n’échappe pas à ce phénomène.
- À l’échelle mondiale : 75 % des milieux terrestres sont altérés de façon significative et plus de 85 % des zones humides ont été détruites (IPBES).
- En France métropolitaine : 32 % des oiseaux nicheurs, 24 % des reptiles, 23 % des amphibiens et 14 % des mammifères sont menacés de disparition du territoire (Ministère de la transition écologique).
En cause : l’urbanisation, les infrastructures de transport et les activités humaines qui détruisent ou fragmentent les milieux naturels ; les pollutions qui dégradent les sols, l’eau et l’air ; la surexploitation des ressources ; les espèces exotiques envahissantes... Le tout étant aggravé par le changement climatique qui modifie les conditions de vie des espèces.
Cette chute de la biodiversité a des effets graves sur notre qualité de vie, notre santé et sur les activités.
Un capital vivant à préserver
Avec ses 635 km2, l’estuaire de la Gironde est le plus vaste estuaire d'Europe. Cet espace d’échanges terre-mer joue un rôle clé dans la reproduction, la nourriture et le repos des espèces aquatiques et des oiseaux. D’autant que notre département est une halte majeure pour les oiseaux migrateurs, entre les pays du sud et du nord.
La Gironde, c’est aussi 3 500 km de cours d’eau, 54 588 ha de zones humides (marais, palus, lagunes…) soit 11 fois la surface de Bordeaux, 126 km de littoral avec un système dunaire unique, des espaces forestiers forgés au cours des millénaires, etc. Cette mosaïque de milieux accueille une biodiversité d’une grande richesse.
Le département de la Gironde développe une politique ambitieuse pour préserver ce patrimoine naturel et paysager : prévenir, expérimenter, gérer, aménager, restaurer, sensibiliser… Autant d’actions menées en lien avec le tissu associatif, les collectivités et de multiples partenaires.